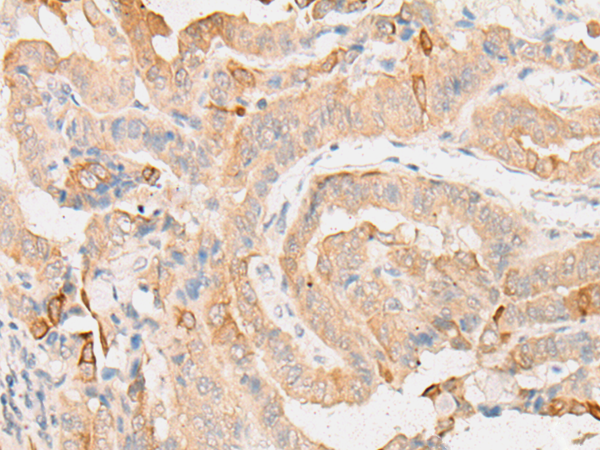

|
Background: |
This gene encodes a translation initiation factor involved in the recruitment and delivery of aminoacyl-tRNAs to the P-site of the eukaryotic ribosome in a GTP-independent manner. This gene was previously referred to as ligatin, but is now known to localize to the cytoplasm and localize and function with translation factors. Multiple transcript variants encoding different isoforms have been found for this gene. |
|
Applications: |
ELISA, IHC |
|
Name of antibody: |
EIF2D |
|
Immunogen: |
Synthetic peptide of human EIF2D |
|
Full name: |
eukaryotic translation initiation factor 2D |
|
Synonyms: |
LGTN; HCA56 |
|
SwissProt: |
P41214 |
|
ELISA Recommended dilution: |
5000-10000 |
|
IHC positive control: |
Human thyroid cancer and Human ovarian cancer |
|
IHC Recommend dilution: |
25-100 |

購(gòu)物車
購(gòu)物車 幫助
幫助
 021-54845833/15800441009
021-54845833/15800441009
